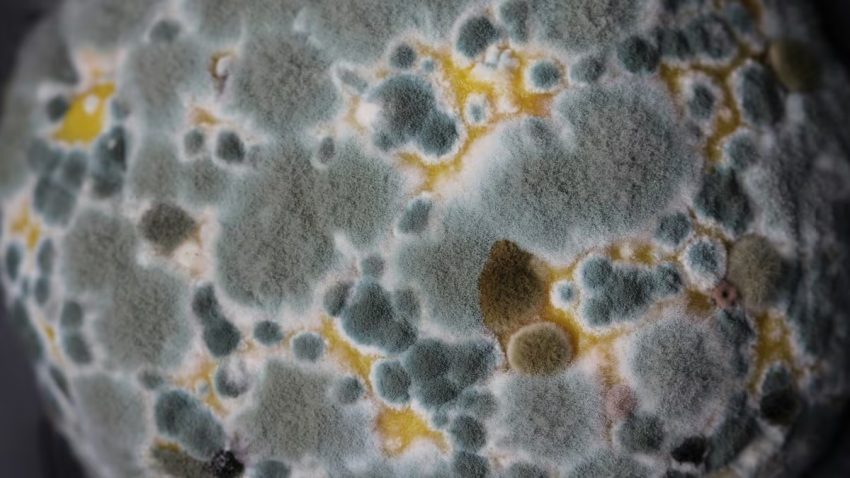

El moho es un problema de salud pública en México, afectando hogares y oficinas. Expertos advierten sobre su impacto en la salud y la economía, con soluciones como ventilación y monitoreo de la calidad del aire.
elfinanciero.com.mx
El moho es una amenaza silenciosa en hogares y oficinas, comprometiendo tanto la salud como la estructura de los inmuebles. En México, la humedad relativa en ciertas regiones favorece su proliferación, y su impacto es subestimado por la falta de información y medidas preventivas.
Isaac Limón entrevistó a Facundo Flores, especialista en calidad del aire, para La Suite de El Financiero, quien explicó que “el moho no solo afecta la salud de las personas, sino que también representa un impacto económico. En los últimos cinco años, el gasto en tratamientos por enfermedades respiratorias relacionadas con el moho ha aumentado en un 25%”.
Según la Organización Mundial de la Salud (OMS), la exposición al moho puede provocar alergias, problemas respiratorios e incluso infecciones pulmonares graves como la aspergilosis. Facundo Flores advierte que la falta de ventilación en espacios cerrados agrava el problema. “Cuatro personas en un hogar pueden generar hasta 20 litros de vapor de agua al día. Si no se disipa, favorece el crecimiento de moho”.
Casos recientes en la Ciudad de México han demostrado cómo la acumulación de humedad en oficinas sin ventilación adecuada ha provocado fatiga crónica y problemas respiratorios en empleados. “Las empresas deben monitorear la calidad del aire con higrómetros y renovar el aire con ventilación mecánica si es necesario”, afirma Flores.
Entre las soluciones recomendadas están el uso de extractores inteligentes, ventilación cruzada y la inspección periódica de ductos de aire acondicionado. En un país donde el 70% de la población pasa la mayor parte del tiempo en espacios interiores, abordar el moho no es solo una cuestión de mantenimiento, sino de salud pública.
Si deseas contactarte con Control Verde y eliminar el moho en cualquier espacio, contáctate a ventas@controlverdemx.com o a los números 5524576777, 5565500360. También puedes contactarlos vía WhatsApp al 55428245.